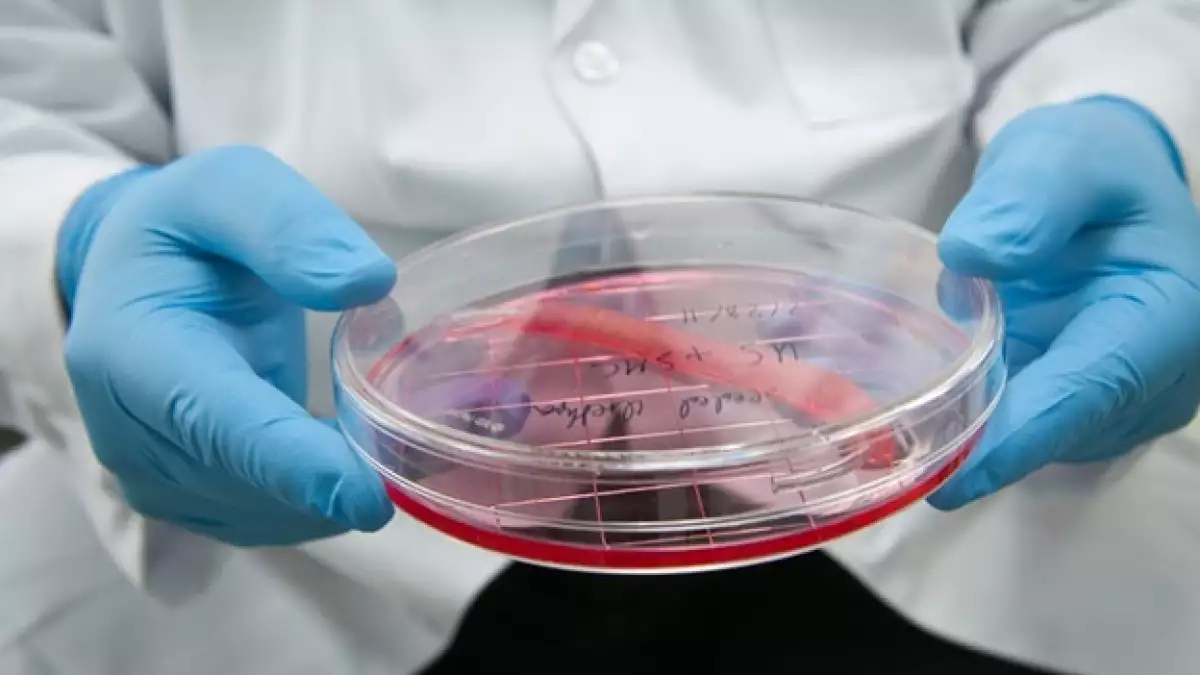

Científicos 'siembran' células y crean nuevos órganos
La ingeniería de órganos comienza con algo que falta —un órgano fantasma en el cuerpo que causa al paciente una increíble incomodidad, disfunción o dolor— y termina con una muestra de la ingeniería estilo ciencia ficción en la que los órganos faltantes son reemplazados con células extraídas del cuerpo del mismo paciente.
En un pequeño estudio piloto publicado el lunes en el Lancet, los científicos reportaron que reconstruyeron exitosamente uretras de cinco jóvenes pacientes con sus propias células.
"Fuimos capaces de crear tejido propio del paciente que pertenece a los sitios donde lo colocamos", explicó el Dr. Anthony Atala, autor principal del estudio y director del Instituto para la Medicina Regenerativa en la Escuela de Medicina de la Universidad Wake Forest.
Las uretras fabricadas con células fueron implantadas en los pacientes entre marzo de 2004 y julio de 2007, en el Hospital Infantil Federico Gómez, en la Ciudad de México. Sus uretras continúan funcionando en los seguimientos después de varios años.
La uretra es un tubo estrecho que conecta la vejiga con los genitales, proveyendo un conducto para transportar los desperdicios fuera del cuerpo. Cuando está dañada —algunas veces congénitamente, o como resultado de un enfermedad, fracturas pélvicas u otros trraumatismos— es usualmente reemplazada con tejido recolectado del revestimiento de las mejillas del paciente o utilizando piel injertada de otra área del cuerpo, de acuerdo con Atala.
"Desafortunadamente, las estrechas estructuras del cuerpo (como las uretras) son un poco complicadas porque tienden a colapsarse", expuso Atala, quien agregó que los reemplazos convencionales de uretra fallan la mitad de las veces.
El reto de los reemplazos tradicionales de uretra es crear un tubo viable que no se colapse fácilmente. Y ahí es donde la ingeniería de órganos puede tener beneficios.
¿Cómo se cultiva una nueva uretra?
El primer paso es tomar una pequeña parte del propio tejido del paciente en el área de la vejiga. Se extraen células del tejido de la biopsia y se les permite multiplicarse , después de lo cual, las células de músculo son separadas de las células de la uretra.
Los siguientes pasos del proceso parecen de ciencia ficción. Cuando existe un número suficiente de células, los científicos las siembran en un andamio de malla que han moldeado con la forma de una uretra. La parte interna de la malla se recubre por células uretrales mientras que la externa se recubre con células musculares.
La estructura sembrada es puesta en una incubadora durante dos semanas, en un proceso que Atala dice que emula el crecimiento de las células dentro del cuerpo.
Después de ese tiempo, la uretra recién construida está lista para ser implantada en el paciente.
“Durante la cirugía nos enfocamos en al área que ha sido dañada, limpiamos el tejido de la cicatriz y colocamos la nueva uretra”, dice Atala. “Suena fácil pero es una cirugía complicada. Es una estructura estrecha que debe encajar adecuadamente”.
De acuerdo con el estudio, los injertos hechos con ingeniería parecían normales tres meses después de haber sido implantados. Las uretras de los pacientes funcionaron normalmente en pocas semanas tras la cirugía y mantuvieron su funcionamiento durante hasta seis años.
Atala acepta que pasarán varios años antes de que la ingeniería de órganos se vuelva la norma, y no queda claro si la misma tecnología funcionará en adultos mayores. Dijo que además de pacientes con disfunción de la uretra, pacientes con otros complejos problemas de los vasos podrían beneficiarse algún día de esta cirugía.
Atala y sus colegas reportaron un éxito similar en siete pacientes con espina bífida , al reemplazar sus vejigas disfuncionales en 2006.
Los científicos de Wake Forest han creado exitosamente en el laboratorio más de 30 tejidos y órganos, incluyendo hígados en miniatura, válvulas cardiacas; incluso han imprimido órganos como piel humana y riñones.
Científicos como Atala dicen que la medicina regenerativa es una nueva frontera que puede ayudar a los médicos a curar, en vez de sólo tratar, enfermedades utilizando la capacidad natural del cuerpo de sanarse a sí mismo.
Sin embargo, aún faltan muchos años para eso. La mayoría de estas tecnologías no están listas para su implantación amplia, y los costos de la medicina regenerativa en esta etapa temprana son a menudo mucho más altos que los procedimientos convencionales.